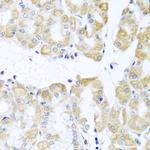
DDX39A Antibody in Immunohistochemistry (Paraffin) (IHC (P))

Search
Invitrogen
DDX39A Polyclonal Antibody
{{$productOrderCtrl.translations['antibody.pdp.commerceCard.promotion.promotions']}}
{{$productOrderCtrl.translations['antibody.pdp.commerceCard.promotion.viewpromo']}}
{{$productOrderCtrl.translations['antibody.pdp.commerceCard.promotion.promocode']}}: {{promo.promoCode}} {{promo.promoTitle}} {{promo.promoDescription}}. {{$productOrderCtrl.translations['antibody.pdp.commerceCard.promotion.learnmore']}}

Please note: We are reviewing Western blot images included in the antibody testing data in our catalog, including those provided by third parties. Unless expressly labeled or annotated as “raw-unedited”, Western blot images included in the antibody testing data in our catalog may have been edited, optimized or otherwise adjusted for presentation.
产品信息
PA5-109624
种属反应
宿主/亚型
分类
类型
抗原
偶联物
形式
浓度
规格
纯化类型
保存液
内含物
保存条件
运输条件
RRID
产品详细信息
Immunogen sequence: MAEQDVENDL LDYDEEEEPQ APQESTPAPP KKDIKGSYVS IHSSGFRDFL LKPELLRAIV DCGFEHPSEV QHECIPQAIL GMDVLCQAKS GMGKTAVFVL
靶标信息
This gene encodes a member of the DEAD box protein family. These proteins are characterized by the conserved motif Asp-Glu-Ala-Asp (DEAD) and are putative RNA helicases. They are implicated in a number of cellular processes involving alteration of RNA secondary structure, such as translation initiation, nuclear and mitochondrial splicing, and ribosome and spliceosome assembly. Based on their distribution patterns, some members of the DEAD box protein family are believed to be involved in embryogenesis, spermatogenesis, and cellular growth and division. This gene is thought to play a role in the prognosis of patients with gastrointestinal stromal tumors. A pseudogene of this gene is present on chromosome 13. Alternate splicing results in multiple transcript variants. Additional alternatively spliced transcript variants of this gene have been described, but their full-length nature is not known.
仅用于科研。不用于诊断过程。未经明确授权不得转售。
篇参考文献 (0)
生物信息学
蛋白别名: ATP-dependent RNA helicase DDX39; ATP-dependent RNA helicase DDX39A; DEAD (Asp-Glu-Ala-Asp) box polypeptide 39; DEAD box protein 39; DEAD/H (Asp-Glu-Ala-Asp/His) box polypeptide 39; Nuclear RNA helicase URH49; Nuclear RNA helicase, DECD variant of DEAD box family; UAP56-related helicase, 49 kDa
基因别名: 2610307C23Rik; BAT1; DDX39; DDX39A; DDXL; URH49
UniProt ID: (Mouse) Q8VDW0, (Rat) Q5U216
Entrez Gene ID: (Mouse) 68278, (Rat) 89827




